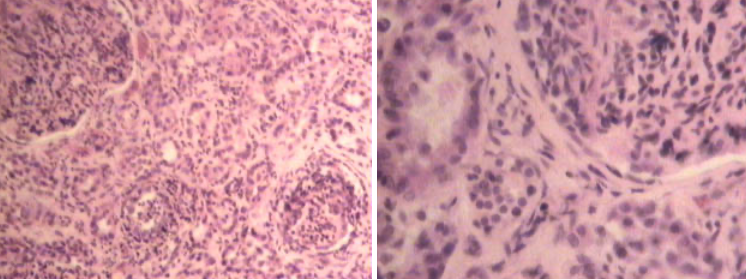
term image
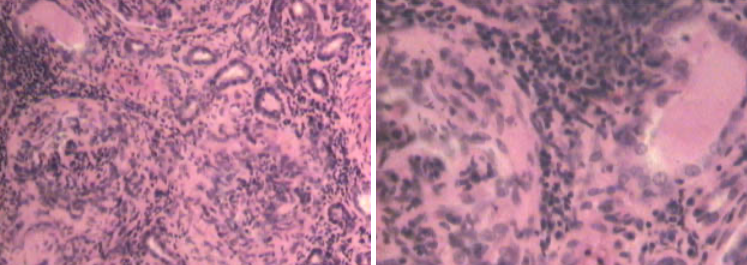
term image

1/42
Looks like no tags are added yet.
Name | Mastery | Learn | Test | Matching | Spaced |
|---|
No study sessions yet.

Verine soolepõletik

Alaäge südamepauna fibrinoos-mädane põletik

Krupoosne kopsupõletik, punase maksanemise staadium

Krupoosne kopsupõletik - halli maksnemise staadium

Difteriitiline soolepõletik

Difteriitne söögitorupõletik

Äge mädane lihasepõletik

Neeru äge mädane põletik

äge katarraalne trahiit

äge katarraalne soolepõletik

krooniline katarraalne soolepõletik

krooniline katarraalne maopõletik

Äge katarraalne bronhopneumoonia

Maksa atroofiline tsiroos

Mkasa hüpertroofiline tsiroos

Äge mittemädane ajupõletik

Tüükaline südamesisekesta põletik

Krooniline fibroosne südamelihase põletik

Lümfosakroom

Maksa lümfoidne leukoos

Maksa mükoloidne leukoos

Kopsude krooniline alveolaarne emfüseem

Roide rahhiit

Kopsu miliaarne tuberkuloos

Kaseoosne tuberkuloosne kopsupõletik

Kõhukelme tuberkuloos

Aju pehmekesta tuberkuloosne põletik

Lümfisõlme tuberkuloosne põletik

Düstroofia ja nekroos südamelihases

Kolloidne struuma ehk kolloidne hõõtsik

Parenhümatoosne struuma

Aktinomükoos

Südamelihase killunemine

Mao seedehaavad

Verine neerupõletik
Alaäge glomerulonefriit
Krooniline glomerulonefriit

Neeru tsüstid

Fastsioloosne sapijuhapõletik

Koktsidioosne sapijuhapõletik

Maksa tsüstitserkoos

Südamelihase sarkotsüstoos

Lihase trihhinelloos